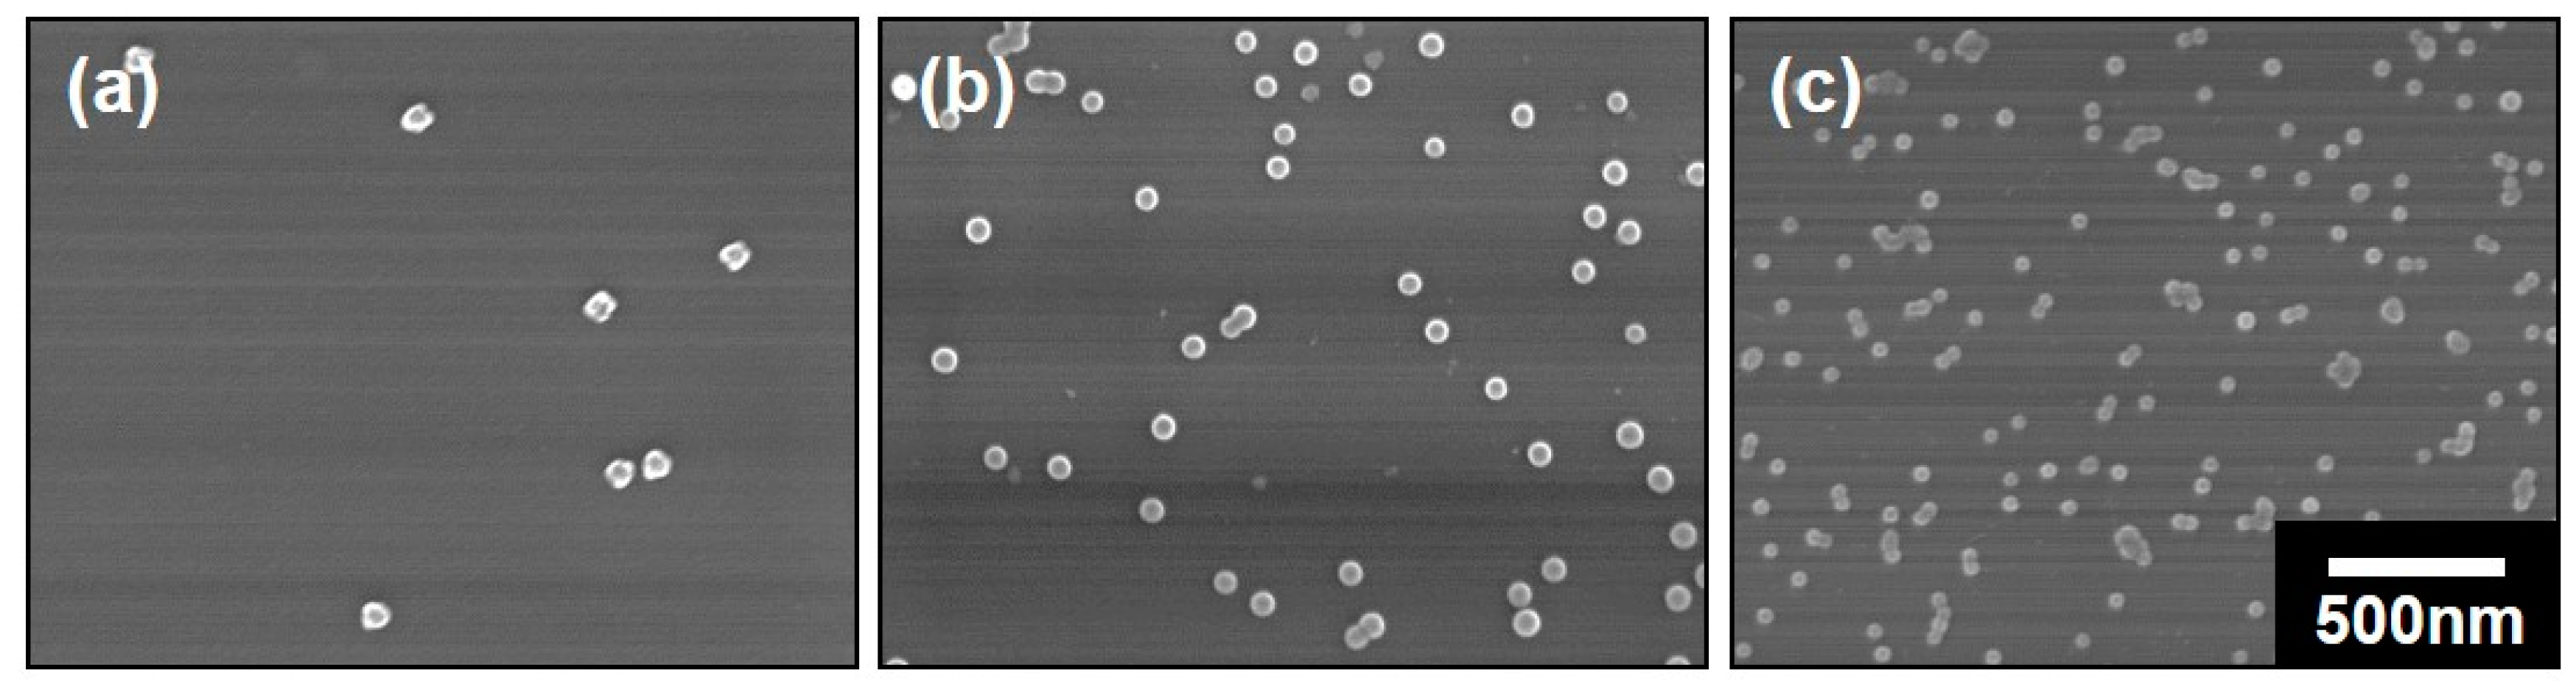
Polymers 11 01208 g003

Synthesis of Double-Shelled Hollow Inorganic Nanospheres through Block Copolymer-Metal Coordination and Atomic Layer Deposition
Abstract
1. Introduction
2. Materials and Methods
2.1. Materials
2.2. Preparation of Polymeric Composite Micelles by Coordination
2.3. Preparation of the DSH Inorganic Nanospheres
2.4. Characterizations
3. Results
3.1. The Polymeric Composite Micelles Prepared by Metal–ligand Coordination
3.2. Preparation of the Nanospheres by ALD on the Polymeric Composite Micelles
3.3. The Preparation of the DSH Inorganic Nanospheres
4. Conclusions
Supplementary Materials
Author Contributions
Funding
Acknowledgments
Conflicts of Interest
References
- Cao, K.Z.; Jiao, L.F.; Liu, H.Q.; Liu, Y.C.; Wang, Y.J.; Guo, Z.P.; Yuan, H.T. 3D hierarchical porous alpha-fe2o3 nanosheets for high-performance lithium-ion batteries. Adv. Energy Mater. 2015, 5, 1401421. [Google Scholar] [CrossRef]
- Li, X.J.; Li, M.Y.; Liang, J.C.; Wang, X.F.; Yu, K.F. Growth mechanism of hollow TiO2(B) nanocrystals as powerful application in lithium-ion batteries. J. Alloys. Compd. 2016, 681, 471–476. [Google Scholar] [CrossRef]
- Zhang, M.; Shang, Q.G.; Wan, Y.Q.; Cheng, Q.R.; Liao, G.Y.; Pan, Z.Q. Self-template synthesis of double-shell TiO2@ZIF-8 hollow nanospheres via sonocrystallization with enhanced photocatalytic activities in hydrogen generation. Appl. Catal. B Environ. 2019, 241, 149–158. [Google Scholar] [CrossRef]
- Xin, W.P.; Gao, T.T.; Zhang, W.Q.; Hu, T.T.; Sun, X.F.; Zhou, G.W. Three-dimensional hollow SnO2@TiO2 spheres encapsulated in reduced graphene oxide aerogels as promising anodes for lithium-ion storage. J. Alloys. Compd. 2019, 784, 157–164. [Google Scholar] [CrossRef]
- Zheng, Y.; Zhou, T.F.; Zhang, C.F.; Mao, J.F.; Liu, H.K.; Guo, Z.P. Boosted charge transfer in SnS/SnO2 heterostructures: Toward high rate capability for sodium-ion batteries. Angew. Chem. Int. Ed. 2016, 55, 3408–3413. [Google Scholar] [CrossRef] [PubMed]
- Zhou, H.Q.; Wang, Y.M.; He, R.; Yu, F.; Sun, J.Y.; Wang, F.; Lan, Y.C.; Ren, Z.F.; Chen, S. One-step synthesis of self-supported porous NiSe2/Ni hybrid foam: An efficient 3D electrode for hydrogen evolution reaction. Nano Energy 2016, 20, 29–36. [Google Scholar] [CrossRef]
- Li, X.G.; Lu, Q.F.; Huang, M.R. Self-stabilized nanoparticles of intrinsically conducting copolymers from 5-sulfonic-2-anisidine. Small 2008, 4, 1201–1209. [Google Scholar] [CrossRef] [PubMed]
- Li, F.B.; Yao, X.P.; Wang, Z.G.; Xing, W.H.; Jin, W.Q.; Huang, J.; Wang, Y. Highly porous metal oxide networks of interconnected nanotubes by atomic layer deposition. Nano Lett. 2012, 12, 5033–5038. [Google Scholar] [CrossRef]
- Joo, S.H.; Ryoo, R.; Kruk, M.; Jaroniec, M. Evidence for general nature of pore interconnectivity in 2-dimensional hexagonal mesoporous silicas prepared using block copolymer templates. J. Phys. Chem. B 2002, 106, 4640–4646. [Google Scholar] [CrossRef]
- Carriazo, D.; Pico, F.; Gutierrez, M.C.; Rubio, F.; Rojo, J.M.; del Monte, F. Block-copolymer assisted synthesis of hierarchical carbon monoliths suitable as supercapacitor electrodes. J. Mater. Chem. 2010, 20, 773–780. [Google Scholar] [CrossRef]
- Abetz, V.; Simon, P.F.W. Phase behaviour and morphologies of block copolymers. In Block Copolymers I.; Abetz, V., Ed.; Springer: Berlin/Heidelberg, Germany, 2005; Volume 189, pp. 125–212. [Google Scholar]
- Yang, Z.M.; Wang, Z.G.; Yao, X.P.; Chen, X.Q.; Wang, Y. Responsive, fluorescent micellar nanospheres of amphiphilic block copolymers for the characterization of membrane pores. J. Membr. Sci. 2013, 441, 9–17. [Google Scholar] [CrossRef]
- Zhang, Z.Z.; Rahman, M.M.; Abetz, C.; Bajer, B.; Wang, J.L.; Abetz, V. Quaternization of a polystyrene-block-poly(4-vinylpyridine) isoporous membrane: An approach to tune the pore size and the charge density. Macromol. Rapid Commun. 2019, 40, 1800729. [Google Scholar] [CrossRef] [PubMed]
- Aizawa, M.; Buriak, J.M. Nanoscale patterning of two metals on silicon surfaces using an ABC triblock copolymer template. J. Am. Chem. Soc. 2006, 128, 5877–5886. [Google Scholar] [CrossRef]
- Ras, R.H.A.; Kemell, M.; de Wit, J.; Ritala, M.; ten Brinke, G.; Leskela, M.; Ikkala, O. Hollow inorganic nanospheres and nanotubes with tunable wall thicknesses by atomic layer deposition on self-assembled polymeric templates. Adv. Mater. 2007, 19, 102–106. [Google Scholar] [CrossRef]
- Xiong, S.; Yang, Y.; Zhong, Z.X.; Wang, Y. One-step synthesis of carbon-hybridized zno on polymeric foams by atomic layer deposition for efficient absorption of oils from water. Ind. Eng. Chem. Res. 2018, 57, 1269–1276. [Google Scholar] [CrossRef]
- Selvaraj, S.K.; Parulekar, J.; Takoudis, C.G. Selective atomic layer deposition of zirconia on copper patterned silicon substrates using ethanol as oxygen source as well as copper reductant. J. Vac. Sci. Technol. A 2014, 32, 010601. [Google Scholar] [CrossRef]
- Feng, J.; Xiong, S.; Wang, Y. Atomic layer deposition of hybrid metal oxides on carbon nanotube membranes for photodegradation of dyes. Compos. Commun. 2019, 12, 39–46. [Google Scholar] [CrossRef]
- Wei, Z.; Akbari, M.K.; Hai, Z.Y.; Ramachandran, R.K.; Detavernier, C.; Verpoort, F.; Kats, E.; Xu, H.Y.; Hu, J.; Zhuiyko, S. Ultra-thin sub-10 nm Ga2O3-WO3 heterostructures developed by atomic layer deposition for sensitive and selective C2H5OH detection on ppm level. Sens. Actuator B Chem. 2019, 287, 147–156. [Google Scholar] [CrossRef]
- Yin, J.; Xu, Q.; Wang, Z.G.; Yao, X.P.; Wang, Y. Highly ordered TiO2 nanostructures by sequential vapour infiltration of block copolymer micellar films in an atomic layer deposition reactor. J. Mater. Chem. C 2013, 1, 1029–1036. [Google Scholar] [CrossRef]
- Wang, Q.Q.; Wang, H.H.; Xiong, S.; Chen, R.Z.; Wang, Y. Extremely efficient and recyclable absorbents for oily pollutants enabled by ultrathin-layered functionalization. ACS Appl. Mater. Interfaces 2014, 6, 18816–18823. [Google Scholar] [CrossRef]
- Porro, S.; Bejtka, K.; Jasmin, A.; Fontana, M.; Milano, G.; Chiolerio, A.; Pirri, C.F.; Ricciardi, C. A multi-level memristor based on atomic layer deposition of iron oxide. Nanotechnology 2018, 29, 9. [Google Scholar] [CrossRef] [PubMed]
- Yan, N.; Qin, L.J.; Li, J.G.; Zhao, F.Q.; Feng, H. Atomic layer deposition of iron oxide on reduced graphene oxide and its catalytic activity in the thermal decomposition of ammonium perchlorate. Appl. Surf. Sci. 2018, 451, 155–161. [Google Scholar] [CrossRef]
- Zhong, L.J.; Chen, F.; Campbell, S.A.; Gladfelter, W.L. Nanolaminates of zirconia and silica using atomic layer deposition. Chem. Mater. 2004, 16, 1098–1103. [Google Scholar] [CrossRef]
- Yang, Z.M.; Wang, Z.G.; Yao, X.P.; Wang, Y. Water-dispersible, uniform nanospheres by heating-enabled micellization of amphiphilic block copolymers in polar solvents. Langmuir 2012, 28, 3011–3017. [Google Scholar] [CrossRef] [PubMed]
- Hamley, I.W. Nanotechnology with soft materials. Angew. Chem. Int. Ed. 2003, 42, 1692–1712. [Google Scholar] [CrossRef] [PubMed]
- Krishnamoorthy, S.; Pugin, R.; Brugger, J.; Heinzelmann, H.; Hinderling, C. Nanopatterned self-assembled monolayers by using diblock copolymer micelles as nanometer-scale adsorption and etch masks. Adv. Mater. 2008, 20, 1962–1965. [Google Scholar] [CrossRef]
- Yuan, J.J.; Ma, R.; Gao, Q.; Wang, Y.F.; Cheng, S.Y.; Feng, L.X.; Fan, Z.Q.; Jiang, L. Synthesis and characterization of polystyrene/poly(4-vinylpyridine) triblock copolymers by reversible addition-fragmentation chain transfer polymerization and their self-assembled aggregates in water. J. Appl. Polym. Sci. 2003, 89, 1017–1025. [Google Scholar] [CrossRef]
- Fan, S.; Luan, Y.; Wang, J.J.; Gao, H.Y.; Zhang, X.W.; Wang, G. Monodispersed poly(4-vinylpyridine) spheres supported Fe(iii) material: An efficient and reusable catalyst for benzylic oxidation. J. Mol. Catal. A Chem. 2015, 404, 186–192. [Google Scholar] [CrossRef]
- Yarapathi, R.V.; Reddy, S.M.; Tammishetti, S. Polymer supported ferric chloride: Regiospecific nucleophilic ring opening of epoxides. React. Funct. Polym. 2005, 64, 157–161. [Google Scholar] [CrossRef]
- Dallorto, S.; Staaks, D.; Schwartzberg, A.; Yang, X.M.; Lee, K.Y.; Rangelow, I.W.; Cabrini, S.; Olynick, D.L. Atomic layer deposition for spacer defined double patterning of sub-10 nm titanium dioxide features. Nanotechnology 2018, 29, 405302. [Google Scholar] [CrossRef]
- Lu, H.; Deng, K.M.; Yan, N.N.; Ma, Y.L.; Gu, B.K.; Wang, Y.; Li, L. Efficient perovskite solar cells based on novel three-dimensional TiO2 network architectures. Sci. Bull. 2016, 61, 778–786. [Google Scholar] [CrossRef]
- Mitchell, D.R.G.; Attard, D.J.; Triani, G. Transmission electron microscopy studies of atomic layer deposition TiO2 films grown on silicon. Thin Solid Films 2003, 441, 85–95. [Google Scholar] [CrossRef]

| Block Copolymers | MnPS | MnP4VP | Polydispersity |
|---|---|---|---|
| PS-b-P4VP-1 | 75,000 | 25,000 | 1.09 |
| PS-b-P4VP-2 | 50,000 | 17,000 | 1.15 |
| PS-b-P4VP-3 | 23,000 | 4,500 | 1.10 |
| Cycles | PS-b-P4VP-1 | PS-b-P4VP-2 | PS-b-P4VP-3 |
|---|---|---|---|
| 0 | 75 ± 5 | 64 ± 4 | 46 ± 4 |
| 50 | 83 ± 4 | 71 ± 3 | 55 ± 4 |
| 100 | 93 ± 7 | 77 ± 4 | 61 ± 5 |
| 300 | 109 ± 5 | 106 ± 5 | 85 ± 6 |
| 500 | 136 ± 6 | 135 ± 5 | 112 ± 6 |
| Element | Weight % | Atomic % |
|---|---|---|
| O K | 6.04 | 10.16 |
| Si K | 93.39 | 89.54 |
| Ti K | 0.32 | 0.18 |
| Fe K | 0.25 | 0.12 |
| Totals | 100.00 |
© 2019 by the authors. Licensee MDPI, Basel, Switzerland. This article is an open access article distributed under the terms and conditions of the Creative Commons Attribution (CC BY) license (http://creativecommons.org/licenses/by/4.0/).
Share and Cite
Yan, N.; Guan, Q.; Yang, Z.; Feng, M.; Jiang, X.; Liu, J.; Xu, L. Synthesis of Double-Shelled Hollow Inorganic Nanospheres through Block Copolymer-Metal Coordination and Atomic Layer Deposition. Polymers 2019, 11, 1208. https://doi.org/10.3390/polym11071208
Yan N, Guan Q, Yang Z, Feng M, Jiang X, Liu J, Xu L. Synthesis of Double-Shelled Hollow Inorganic Nanospheres through Block Copolymer-Metal Coordination and Atomic Layer Deposition. Polymers. 2019; 11(7):1208. https://doi.org/10.3390/polym11071208
Chicago/Turabian StyleYan, Nina, Qingbao Guan, Zhiming Yang, Min Feng, Xizhi Jiang, Jun Liu, and Lei Xu. 2019. "Synthesis of Double-Shelled Hollow Inorganic Nanospheres through Block Copolymer-Metal Coordination and Atomic Layer Deposition" Polymers 11, no. 7: 1208. https://doi.org/10.3390/polym11071208
APA StyleYan, N., Guan, Q., Yang, Z., Feng, M., Jiang, X., Liu, J., & Xu, L. (2019). Synthesis of Double-Shelled Hollow Inorganic Nanospheres through Block Copolymer-Metal Coordination and Atomic Layer Deposition. Polymers, 11(7), 1208. https://doi.org/10.3390/polym11071208

